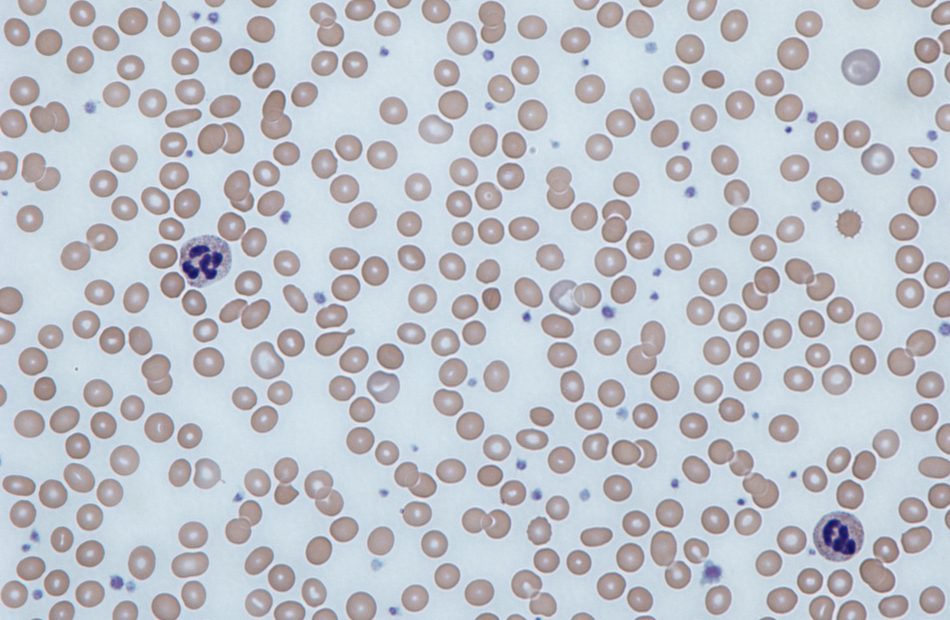

Wellness Packages
We offer a comprehensive range of laboratory tests, including clinical chemistry, microbiology, and molecular diagnostics.


Our wellness test are a comprehensive health check-up that includes various screenings, physical exams, and counseling to assess and maintain both woman’s and men,s overall health and well-being including children. These exams are crucial for early detection of potential health issues and promoting preventative care.

Biocheckup
is a comprehensive health screening service that uses advanced diagnostic tools to assess your overall health. It provides detailed insights into vital biomarkers, helping you detect potential health issues early and make informed lifestyle or medical decisions..
Special Requirements
-Fasting from 10 to 12 hours
Profile Test Includes:
- Bilirubin, Direct, Serum
- Alanine Aminotransferase (ALT,GPT), Serum
- High Density Lipoprotein (HDL) Cholesterol, Serum
- Triglycerides, Serum
- Chloride, Serum
- Non HDL Cholesterol, Serum
- Fasting Blood Sugar (Glucose), Serum
- Bilirubin, Total, Serum
- Estimated Glomerular Filtration Rate Level, Serum
- Creatinine, Serum
- Uric Acid, Serum
- Potassium, Serum
- Triglycerides-to-HDL Ratio, Serum
- Globulin, Serum
- Cholesterol/HDL Ratio, Serum
- Complete Blood Count
- C-Reactive Protein, Serum
- Erythrocyte Sedimentation Rates first hour, Blood
- Albumin, Serum
- Albumin / Globulin Ratio, Serum
- Cholesterol, Total, Serum
- Urine Analysis
- Gamma-Glutamyl Transferase Serum
- Aspartate Aminotransferase Serum
- Urea, Serum
- Sodium, Serum
- Low Density Lipoprotein Cholesterol, Direct, Serum
- Protein, Total, Serum

Bio Hair and Nail
are specialized forensic or medical tests used to detect long-term exposure to drugs, toxins, or nutritional deficiencies. Because hair and nails grow slowly and incorporate substances from the bloodstream over time, they can provide a historical record of exposure
Special Requirements
–
Profile Test Includes:
- Ferritin, Serum
- Magnesium, Serum
- Thyroid Stimulating Hormone, Serum
- Calcium, Serum
- Testosterone, Total, Serum
- Zinc, Serum
- Complete Blood Count (without blood film)

BioJuniors
is a comprehensive health designed for children to ensure their overall well-being and monitor the health of young individuals, offering peace of mind to parents.
Special Requirements
–
Profile Test Includes:
- Calcium, Serum
- Ferritin, Serum
- 25-hydroxy Vitamin D Total, Serum
- Complete Blood Count (without blood film)
- Erythrocyte Sedimentation Rate first hour, Blood
- Vitamin B12 (Cobalamin), Serum
- Urine Analysis
- Random Blood Glucose, Serum

BioCardiac Risk
refers to the likelihood of an individual developing heart-related conditions, such as heart attack, stroke, or coronary artery disease. It is influenced by factors like high blood pressure, high cholesterol, smoking, diabetes, obesity, lack of exercise, poor diet, and family history.
Special Requirements
–
Profile Test Includes:
- Cardiovascular Disease Associated Risk.
- 12 Mutation Profile, PCR

Injection Weight Control
Injection weight control refers to the precise regulation of the amount of material injected into a mold during the injection molding process. Maintaining consistent injection weight is crucial for ensuring product quality, dimensional accuracy, and structural integrity.
Special Requirements
-Fasting from 10 to 12 hours
Profile Test Includes:
- Urine Analysis
- Insulin, Fasting, Serum
- Fasting Blood Sugar (Glucose), Serum
- Homa Scope (HOMA2-IR), Serum
- Glycosylated Hemoglobin, EDTA Blood
- Uric Acid, Serum
- Potassium, Serum
- Triglycerides-to-HDL Ratio, Serum
- Estimated Average Glucose, EDTA Blood
- Medical consultation 34, Injectables
- Complete Blood count (CBC) without blood film)
- Thyroid Stimulating Hormone (TSH), Serum
- Lipase, Serum
- Triglycerides, Serum
- Non HDL Cholesterol, Serum
- Gamma-Glutamyl Transferase (g-GT), Serum
- Cholesterol, Total, Serum
- Chloride, Serum
- Alanine Aminotransferase (ALT/GPT), Serum
- Creatine, Serum
- Amylase, Serum
- High Density Lipoprotein (HDL) Cholesterol, Serum
- Estimated Glomerular Filtration Rate Level, Serum
- Cholesterol / HDL Ratio, Serum
- Aspart

BioThyroid
The thyroid is a small, butterfly-shaped gland located at the base of the neck that plays a vital role in regulating the body’s metabolism through the release of hormones like thyroxine (T4) and triiodothyronine (T3). These hormones influence various bodily functions, including heart rate, temperature regulation, and energy levels.
Special Requirements
–
Profile Test Includes:
- Anti Thyroid Peroxidase (TPO) Antibodies, Serum
- Thyroxine (FT4), Free, Serum
- Triiodothyronine (FT3), Free, Serum
- Thyroid Stimulating Hormone (TSH), Serum

BioDiabetes
typically includes tests like fasting blood glucose, HbA1c (glycated hemoglobin), postprandial blood sugar, and sometimes insulin levels and lipid profile, to assess blood sugar control and overall metabolic health.
Special Requirements
–
Profile Test Includes:
- Non HDL Cholesterol, Serum
- Triglycerides, Serum
- Urine Analysis
- Alanine Aminotransferase (ALT/GPT), Serum
- Cholesterol, Total, Serum
- High Density Lipoprotein (HDL) Cholesterol, Serum
- Creatine, Serum
- Aspartate Aminotransferase (AST/GOT), Serum
- Complete Blood Count (CBC) (without blood film)
- Uric Acid, Serum
- Albumin-t0-creatine ratio (ACR), random urine
- Glycosylated Hemoglobin (HbA1c), EDTA blood
- Triglycerides-to-HDL Ratio, Serum
- Estimate Average Glucose, EDTA Blood
- Cholesterol / HDL Ratio, Serum
- Estimated Glomerular Filtration Rate Level, Serum
- Fasting Blood Sugar (Glucose), Serum
- Gamma-Glutamyl Transferase (g-GT), Serum
- Low Density Lipoprotein (LDL) Cholesterol, Serum

BioDiet & Fitness
A bio diet and fitness profile test usually includes assessments of body composition (BMI, fat percentage, muscle mass), metabolic rate, blood sugar levels, lipid profile, vitamin and mineral levels, and sometimes hormone and thyroid function, helping to tailor diet and exercise plans to individual health needs.
Special Requirements
–
Profile Test Includes:
- Cardiovascular Disease Associated Risk.
- 12 Mutation Profile, PCR

BioThrombosis
Bio thrombosis refers to the formation of blood clots in the vessels due to imbalances in the body’s natural clotting and anti-clotting mechanisms. A bio thrombosis profile test is a group of blood tests used to assess a person’s risk of developing abnormal blood clots (thrombosis).
Special Requirements
–
Profile Test Includes:
- Protein C Functional Level
- Protein S Free, (Antigen Assay)
- Prothrombin (F2) G20210A Mutation, PCR, Blood
- Activated Protein C Resistance (Factor V Leiden G1691A mutation), by PCR
- MTHFR Gene Mutation (C677T), PCR, Blood
- MTHFR Gene Mutation (A1298C), PCR, Blood
- Anti Thrombin lll, Plasma
- Lupus Anticoagulant (LAC), Plasma
- Anti Cardiolipin Antibodies, IgG, Serum
- Anti Cardiolipin Antibodies, IgM, Serum
- Anti Phospholipid Antibodies, IgG, Serum
- Anti Phospholipid Antibodies, IgM, Serum

BioMenopause
Bio menopause is the natural biological transition in a woman’s life when menstrual cycles permanently stop, typically between the ages of 45 and 55. It occurs due to a gradual decline in the ovaries’ production of hormones like estrogen and progesterone.
Special Requirements
–
Profile Test Includes:
- Calcium, Serum
- Ferritin, Sum
- Follicle Stimulating Hormone (FSH), Serum
- Luteinizing Hormone (LH), Serum
- 17-beta-Estradiol (E2), Serum
- Prolactin, ,Serum
- Thyroid Stimulation Hormone (TSH), Serum
- Parathyroid Hormone (PTH), Plasma
- 25-hydroxy Vitamin D Total, Serum
BioAnemia 2
typically refers to a comprehensive blood test panel used to diagnose and evaluate the causes of anemia. This panel helps differentiate between types of anemia such as iron-deficiency, vitamin B12/folate deficiency, or chronic disease-related anemia.
Special Requirements
- Fasting From 10-12 Hour
Profile Test Includes:
- Total Iron Binding Capacity (TIBC), Serum
- Ferritin, Serum
- Iron, Serum
- Unsaturated Iron Binding Capacity, Serum
- Complete Blood Count (CBC)
- Vitamin B12 (Cobalamin), Serum
- Folate, (Vitamin B9), Serum

Body Building Profile
A set of medical and fitness tests designed to assess key health markers that support muscle growth, performance, and recovery. These tests help tailor nutrition, training, and supplementation for optimal bodybuilding results while monitoring health risks.
Special Requirements
–
Profile Test Includes:
- C-Reactive Protein High Sensitivity (hs-CRP), Cardiac, Serum
- Cholesterol, Total, Serum
- Aspartate Aminotransferase (AST/GOT), Serum
- Ferritin, Serum
- Thyroid Stimulating Hormone (TSH), Serum
- Triglycerides-to-HDL Ratio, Serum
- Chloride, Serum
- Calcium, Corrected, Serum
- Prolactin, Serum
- Uric Acid, Serum
- Albumin, Serum
- Calcium, Serum
- Testosterone, Free, Serum
- Testosterone, Total, Serum
- Urine Analysis
- High Density Lipoprotein (HDL), Cholesterol, Serum
- Luteinizing Hormone (LH), Serum
- Protein, Total, Serum
- Estimated Glomerular Filtration Rate Level, Serum
- Albumin / Globulin Ratio, Serum
- Follicle Stimulation Hormone (CBC) (without blood film)
- Globulin, Serum
- Fasting Blood Sugar (Glucose), Serum
- Cholesterol / HDL Ratio, Serum
- Creatinine, Serum
- Potassium, Serum
- 17-beta-Estraiol (E2), Serum
- Sodium, Serum
- Alanine Aminotransferase (ALT/GPT), Serum
- Non HDL Cholesterol, Serum
- Low Density lipoprotein (LDL) Cholesterol, Serum

BioVitamins
Bio Vitamins refers to a blood test panel that measures the levels of essential vitamins in the body to assess nutritional status and detect deficiencies. This profile helps identify deficiencies that may lead to fatigue, poor immunity, anemia, or other health issues, and guides dietary or supplement adjustments.
Special Requirements
-Fasting from 2 to 4 hours
Profile Test Includes:
- Vitamin B6 (Pyridoxine), Serum
- 25-hydroxy Vitamin D Total, Serum
- Vitamin K1, EDTA Plasma
- Vitamin B2 (Riboflavin), Blood Level
- Vitamin B12 (Cobalamin), Serum
- Vitamin A (Retinol), Serum Level
- Vitamin E 9alpha tocopherol), Serum Level
- Folate, (Vitamin B9), Serum
- Vitamin B1 (Thiamine pyrophosphate), Blood Level

BioHeart Protect
Bio Heart Protect is a health test profile designed to assess cardiovascular health and identify risk factors for heart disease. This profile helps in early detection and prevention of cardiovascular conditions by guiding lifestyle or treatment interventions.
Special Requirements
- Fasting from 10 – 12 Hours
Profile Test Includes:
- Cholesterol / HDL Ratio, Serum
- Fasting Blood Sugar (Glucose)< Serum
- Aspartate Aminotransferase (AST/GPT), Serum
- Triglycerides, Serum
- Triglycerides-to-HDL Ratio, Serum
- Cholesterol, Total, Serum
- Apolipoprotein A1, Serum
- Apolipoprotein B, Serum
- Gamma-Glutamyl Transferase (g-GT), Serum
- Urine Analysis
- Chlorides, Serum
- Non HDL Cholesterol, Serum
- Creatinine, Serum
- High Density Lipoprotein (HDL) Cholesterol, Serum
- Potassium, Serum
- Uric Acid, Serum
- Bilirubin, Total, Serum
- Estimated Glomerular Filtration Rate Level, Serum
- Glycosylated Hemoglobin (HbA1c), EDTA Blood
- Alkaline Phosphatase, Serum
- C-Reactive Protein High Sensitivity (hs-CRP), Cardiac, Serum
- Sodium, Serum
- Complete Blood count (CBC)
- Erythrocyte Sedimentation Rate (ESR) first hour, Blood
- Estimated Average Glucose, EDTA Blood
- Low Density Lipoprotein (LDL) Cholesterol, Serum

BioDouble Checkup
Bio Double Check-Up – Female Tumor Markers Profile is a comprehensive diagnostic test panel aimed at early detection and monitoring of cancers specific to women.
Special Requirements
-Fasting from 10-12 hours
Profile Test Includes:
- Gamma-Glutamyl Transferase (g-GT)
- C- Reactive Protein, Serum
- Bilirubin, Total, Serum
- Albumin, Serum
- Complete Blood count 9CBC)
- Albumin / Globulin Ratio, Serum
- Cholesterol, Total, Serum
- Uric Acid, Serum
- Carbohydrate Antigen 19-9 (CA 19-9), Serum
- Erythrocyte Sedimentation Rate (ESR) first hour, Blood
- Triglycerides, Serum
- Globulin, Serum
- Potassium, Serum
- Triglycerides-to-HDL Ratio, Serum
- Creatinine, Serum
- Estimated Glomerular Filtration Rate Level, Serum
- Cholesterol / HDL Ratio, Serum
- Fasting Blood Sugar (Glucose), Serum
- Alanine Aminotransferase (ALT/GPT), Serum
- Sodium, Serum
- Protein, Total, Serum
- Urea, Serum
- Alkaline Phosphates, Serum
- Carbohydrate Antigen 15-3 (CA 15-3), Serum
- Carcinoembryonic Antigen (CEA), Serum
- Carbohydrate Antigen 125 (CA 125), Serum
- Aspartate Aminotransferase (AST/GOT),Serum
- Hight Density Lipoprotein (HDL) Cholesterol, Serum
- Urine Analysis
- Chloride, Serum
- Non HDL Cholesterol, Serum
- Bilirubin, Direct, Serum
- Low Density Lipoprotein (LDL) Cholesterol, Serum

BioMen
Bio Men is a health check-up profile tailored specifically for men, focusing on key markers that assess overall wellness, hormonal balance, and risk factors for common male health conditions.
Special Requirements
–
Profile Test Includes:
- Testosterone, Total, Serum
- Prostate Specific Antigen (PSA), Total, Serum
- Prostate Specific Antigen, free, Serum
- Testosterone, Free, Serum
- 25-hydroxy Vitamin D Total, Serum
- Free/ Total PSA Ratio, Serum
- Vitamin B12 (Cobalamin), Serum
- Glycosylated Hemoglobin (HbA1c), EDTA Blood
- Estimated Average Glucose, EDTA Blood

BioFamily
Bio Family is a comprehensive health check-up profile designed for all family members, focusing on preventive care and early detection of common health issues. This profile is suitable for routine health monitoring of adults and children, helping families stay proactive about their well-being.
Special Requirements
-Fasting from 2-4 hours
Profile Test Includes:
- Zinc, Serum
- 25-hydroxy Vitamin D Total, Serum
- Ferritin. Serum
- Thyroid Stimulating Hormone (TSH), Serum
- Calcium, Serum
- Magnesium, Serum
- Iron, Serum

BioMom to be
A specialized health check-up profile designed for women who are pregnant or planning pregnancy. It focuses on essential markers to ensure maternal health and support a healthy pregnancy. This profile helps monitor the mother’s health and identify potential risks early, supporting a safe and healthy pregnancy journey
Special Requirements
–
Profile Test Includes:
- Hepatitis B Surface Antigen (HBsAg)
- Hepatitis C Virus Total Antibodies, Serum
- Blood Group and Rh Typing
- Complete Blood Count (CBC)
- Random Blood Glucose, Serum
- Thyroid Stimulation Hormone (TSH), Serum
- Rubella Antibodies, IgG, Serum
- Urine Analysis

Celiac Profile
A Celiac Profile is a group of blood tests used to screen for celiac disease, an autoimmune condition triggered by gluten (found in wheat, barley, and rye). If blood tests suggest celiac disease, diagnosis is typically confirmed with an intestinal biopsy. The profile is most accurate when the person is still eating gluten regularly.
Special Requirements
–
Profile Test Includes:
- Anti Tissue Transglutaminase Ab, IgG, Serum
- Anti Endomysial Antibodies, IgG, Serum
- Anti Deamidated Gliadin Antibodies, IgG, Serum

BioArthritis 2
Bio Arthritis is a diagnostic test profile designed to detect and monitor different types of arthritis, including rheumatoid arthritis, osteoarthritis, and autoimmune-related joint conditions. This profile helps diagnose the type and severity of arthritis and guides treatment decisions for joint pain and inflammation.
Special Requirements
–
Profile Test Includes:
- Erythrocyte Sedimentation Rate (ESR) first hour, Blood
- Uric Acid, Serum
- C-Reactive Protein, Serum
- Rheumatoid factor (RF), Serum
- Anti Nuclear Antigens (ANA) Antibodies
- Anti Streptolysin O (ASO) Antibodies, Serum
- Anti Extractable Nuclear Antigens (ENA) Antibodies (19 antigens), Serum
- Anti Cyclic Citrullinated People (CCP) Antibodies, Serum

Extended STDs 1
Extended STDs 1 is a comprehensive screening panel designed to detect multiple sexually transmitted diseases (STDs) through blood and urine tests. This profile is recommended for routine sexual health screening, high-risk individuals, or those with symptoms, helping ensure early detection and treatment.
Special Requirements
–
Profile Test Includes:
- Hepatitis B Surface Antigen (HBsAg), Serum
- Hepatitis C Virus Total Antibodies, Serum
- Human Immunodeficiency Virus 1 & 2 Antibodies / Antigen Assay (Combo), Serum
- Sexually Transmitted Disease (STDs) Panel by PCR, Body Fluid

Foreign Labor 1
Foreign Labor 1 is a medical screening profile commonly required for individuals undergoing medical clearance for overseas employment. It ensures the candidate is fit for work and free from infectious or chronic conditions that could pose public health risks.
Special Requirements
- Fasting for at least 8 Hours
Profile Test Includes:
- Hepatitis B Surface (HBsAg), Serum
- Hepatitis C Virus Total Antibodies, Serum
- Complete Blood Sugar (Glucose) (without blood film
- Fasting food Sugar (Glucose), Serum
- Beta-hCG, Qualitative
- Rapid Plasma Reagin (RPR) Test, Qualitative, Serum
- Human Immunodeficiency Virus 1 &2 Antibodies/ Antigen Assay (Combo), Serum
- Urine Analysis

Foreign Labor 2
Foreign Labor 2 is an extended medical screening profile typically required for workers applying for employment abroad, especially in roles involving healthcare, food handling, or physical labor. It builds upon Foreign Labor 1 with additional tests for a more thorough health evaluation.
Special Requirements
-Fasting for at least 8 hours
Profile Test Includes:
- Hepatitis B Surface (HBsAg), Serum
- Hepatitis C Virus Total Antibodies, Serum
- Complete Blood Sugar (Glucose) (without blood film
- Fasting food Sugar (Glucose), Serum
- Beta-hCG, Qualitative
- Rapid Plasma Reagin (RPR) Test, Qualitative, Serum
- Human Immunodeficiency Virus 1 &2 Antibodies/ Antigen Assay (Combo), Serum
- Urine Analysis
- Interferon-Gamma Release Assay (IGRA), QuantiFERON-TB Gold Plus
WHY CHOOSE US
Cutting-edge testing technologies
Fast and accurate results
Confidential and secure data handling
Personalized wellness insights
Supportive guidance for follow-up care
Location
Stand No.8
Shabalala Trust
Hazyview
1242
Bushbuckridge
Hoedspruit
Acornhoek
Elukwatini
Caroline
Tonga
Contact
PHONE:
013 736 1510
076 013 6413
Pathlife
Our team of experienced laboratory professionals utilizes state-of-the-art equipment and follows strict quality control protocols to ensure the highest standards of accuracy and reliability.
